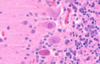
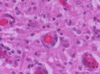
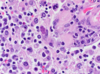
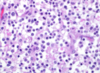

Neuro Images Flashcards
(97 cards)
Name the outer fibrous layer on this brain.

Dura mater
What are these cells?
What do they line?

Ependymal cells
Line ventricles
What is this structure and what is it’s function?

Choroid plexus
Function: produces CSF within the ventricles

What type of cells are seen and what are their function?

Gitter cells (foamy cytoplasm)
Function: microglia that ingest myelin debris
This image shows chromatolysis.
What is chromatolysis?

Degenerative change; dispersal of nissl substance
What do the eosinophilic cells represent?

Neuronal necrosis
“Red is dead”
Name & describe the pathologic process in this image.

Neuronophagia
Migroglia surround necrotic neuron & phagocytose it to remove the debris
Name & describe this large cell shown here.

Spheroid
Focal axonal swelling filled with degenerate organelles - the first step to Wallerian degeneration
Name the pathologic process.
Name & describe the predominant cell type.

Astrocytosis
Gemistocytic astrocytes: plump, reactive astrocytes with eosinophilic cytoplasm
Name the pathologic process.
Name & describe the predominant cell type.
What are these cells typically seen with?

Astrocytosis
Alzheimer’s type II astrocytes: enlarged, vesicular nuclei
Typical of hepatic encephalopathy
Name the pathologic process.

Hydrocephalus
Name the pathologic process.

Hydrocephalus
Name the pathologic process.

Hydrocephalus
Name & describe the pathologic process (shown on right).

Microencephaly
Abnormally small brain
Name the pathologic process and which species this is considered “pathologic”.

Lissencephaly
Pathologic for any domestic mammal
Non-pathologic for some mammals & everything else that is not a mammal
Name & describe the pathologic process.

Prosencephalic hypoplasia (AKA cerebral aplasia)
Absence of the cerebral hemispheres with preservation of at least some portion of the brainstem
Name & describe the pathologic process.

Prosencephalic hypoplasia (AKA cerebral aplasia)
Absence of the cerebral hemispheres with preservation of at least some portion of the brainstem
Name & describe the pathologic processes.

Cranium bifidum & meningoencephalocele
Cranium bifidum: defect through which the brain/spinal cord and meninges can protrude; almost always on dorsal midline
Meningoencephalocele: herniation of meninges and brain/spinal cord
Name & describe the pathologic processes.

Cranium bifidum & meningoencephalocele
Cranium bifidum: defect through which the brain/spinal cord and meninges can protrude; almost always on dorsal midline
Meningoencephalocele: herniation of meninges and brain/spinal cord
Name & describe the pathologic processes.

Cranium bifidum & meningocele
Cranium bifidum: defect through which the brain/spinal cord and meninges can protrude; almost always on dorsal midline
Meningocele: herniation of meninges
Name & describe the pathologic processes.

Spina bifida & meningocele
Spina bifida: defect through which the brain/spinal cord and meninges can protrude; almost always on dorsal midline
Meningocele: herniation of meninges
Name & describe the pathologic process.

Spina bifida
Spina bifida: defect through which the brain/spinal cord and meninges can protrude; almost always on dorsal midline
Name & describe the pathologic process.

Hydranencephaly
Near complete or complete absence of the cerebral hemispheres,
leaving fluid-filled sacs formed by the meninges filled with CSF
Name & describe the pathologic process.

Porencephaly
Cystic cavitation of the brain, usually involving cerebral white matter